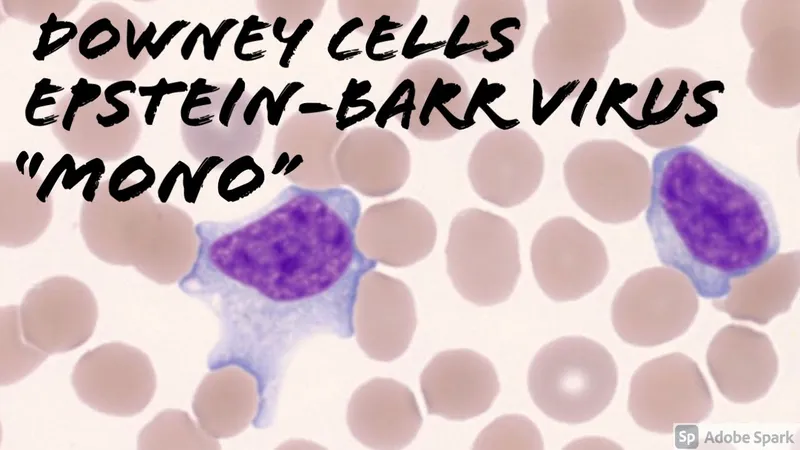
Downey cells in Epstein-Barr virus infection

EBV Virology - The Kissing Virus

- Family: Herpesviridae (Human herpesvirus 4, HHV-4).
- Structure: Large, enveloped virus with an icosahedral capsid containing a linear double-stranded DNA (dsDNA) genome.
- Transmission: Primarily through saliva (hence, "The Kissing Disease").
- Cellular Tropism: Targets oropharyngeal epithelial cells and B-lymphocytes by binding to the CD21 receptor.
⭐ EBV immortalizes B-cells by establishing a lifelong latent infection in memory B-cells, a critical step for its oncogenic potential.
Pathogenesis - B‑Cell Hijacker
EBV infects oropharyngeal epithelial cells and B-lymphocytes. Viral glycoprotein gp350 binds to the B-cell's CD21 receptor for entry, establishing lifelong latency within the memory B-cell pool. Viral proteins (LMPs, EBNAs) mimic constitutive activation signals (like CD40), driving relentless proliferation and preventing apoptosis. This "immortalizes" the B-cell, increasing the risk of malignant transformation.
⭐ EBV cleverly uses the CD21 receptor to enter B-cells. This receptor's normal job is to bind the C3d complement component, linking innate and adaptive immunity.

Infectious Mononucleosis - The Mono Show
- Classic Triad: Fever, lymphadenopathy (posterior cervical), and exudative pharyngitis.
- Also, profound fatigue and malaise.
- Key Finding: Splenomegaly, present in ~50% of cases.
- ⚠️ High risk of splenic rupture with contact sports/trauma.
- Lab Diagnosis:
- Monospot test: Detects heterophile antibodies. Can be negative early in the illness.
- Peripheral smear: Shows atypical lymphocytes (Downey cells).
⭐ Ampicillin Rash: A maculopapular rash frequently develops following administration of ampicillin or amoxicillin, but it is not a true drug allergy.
📌 Mnemonic (MONO):
- Monospot test
- Occipital (posterior cervical) lymphadenopathy
- No contact sports
- Only supportive care
Oncogenesis - Malignant Transformation
- EBV infects B-lymphocytes via the CD21 receptor, promoting cell growth and immortalization.
- Key viral oncoproteins drive malignant transformation:
- LMP-1 (Latent Membrane Protein 1): A functional mimic of the CD40 receptor. It constitutively activates NF-κB and JAK/STAT pathways, upregulating anti-apoptotic proteins like Bcl-2.
- EBNA-2 (EBV Nuclear Antigen 2): Transactivates host genes, including cyclin D, promoting cell cycle progression.
- This leads to polyclonal B-cell proliferation, which can result in malignancy if T-cell immunosurveillance is impaired.

⭐ The classic t(8;14) translocation in Burkitt lymphoma places the c-myc oncogene next to a highly active immunoglobulin heavy-chain promoter, leading to its overexpression.
Diagnosis - Lab Detectives
- Monospot Test: Rapidly detects heterophile antibodies (IgM) that agglutinate non-human RBCs. Note: Can be negative in the first week of illness or in young children.
- Peripheral Smear: Hallmark is a lymphocytosis with >10% atypical lymphocytes (Downey cells).
- EBV-Specific Antibodies: Definitive test if Monospot is negative.
- VCA IgM: Acute infection.
- VCA IgG: Acute/past infection.
- EBNA: Past infection only.
⭐ Atypical lymphocytes are not the infected B cells, but the reactive cytotoxic T-lymphocytes (CD8+) responding to the infection.
- Epstein-Barr virus (EBV), a herpesvirus, primarily targets B-cells via the CD21 receptor, establishing a latent infection.
- Causes infectious mononucleosis ("kissing disease"), diagnosed by heterophile antibodies (Monospot test) and atypical lymphocytes.
- Strongly linked to cancers like Burkitt lymphoma (especially endemic African type), nasopharyngeal carcinoma, and mixed-cellularity Hodgkin lymphoma.
- In immunocompromised patients, it's associated with primary CNS lymphoma and oral hairy leukoplakia.
Unlock the full lesson and continue reading
Signup to continue reading this lesson and unlimited access questions, flashcards, AI notes, and more